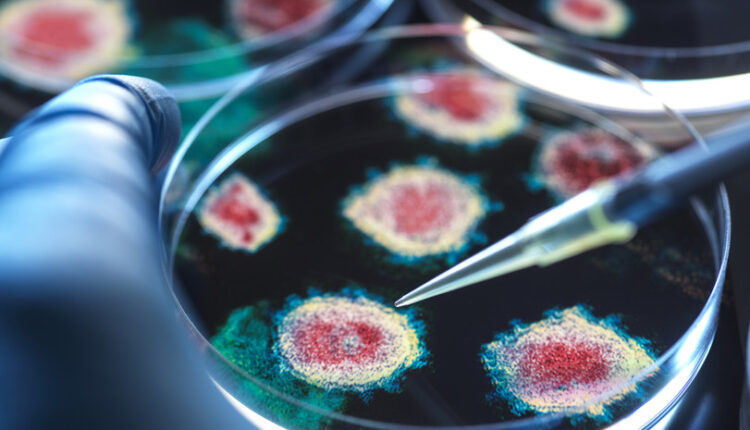

Учёные Сингапура: респираторно-синцитиальный вирус может быть схож с COVID-19
Респираторно-синцитиальный вирус, часто принимаемый за простуду, может быть сопоставим по тяжести и долгосрочному негативному влиянию на здоровье с гриппом и коронавирусной инфекцией COVID-19, выяснили исследователи в Сингапуре.
Как сообщает пресс-служба Сингапурской больницы общего профиля, результаты трёх крупных когортных исследований показали, что риск сердечных и других долгосрочных осложнений у пациентов с РСВ-инфекцией, требующей госпитализации, сопоставим со случаями гриппа и COVID-19.
Анализ около 13 тыс. случаев госпитализации взрослых в связи с РСВ, COVID-19 и гриппом, показал, что от РСВ погибает каждый 20-й (5%) пациент. Таким образом, смертность от РСВ оказалась выше, чем при гриппе, а тяжесть болезни сопоставима с COVID-19.
При этом у каждого десятого (10%), попавшего в больницу с РСВ, диагностировали проблемы с сердечно-сосудистой системой, что также выше, чем от коронавируса.
Кроме того, исследование продемонстрировало, что у взрослых пациентов, перенёсших РСВ, в течение 300 дней после госпитализации сохранялся повышенный риск развития долгосрочных сердечно-сосудистых и неврологических осложнений, а у детей — более высокий, чем при гриппе и коронавирусе, риск респираторных осложнений.
Ранее иммунолог кандидат медицинских наук Николай Крючков рассказал, что продолжительную простуду можно назвать «сборной солянкой» из различных ОРВИ и гриппа.

Комментарии закрыты.